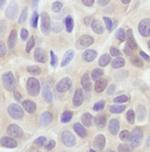
AKT Pan Antibody in Immunohistochemistry (Paraffin) (IHC (P))

Search
Invitrogen
AKT Pan Monoclonal Antibody (E.32.10)
{{$productOrderCtrl.translations['antibody.pdp.commerceCard.promotion.promotions']}}
{{$productOrderCtrl.translations['antibody.pdp.commerceCard.promotion.viewpromo']}}
{{$productOrderCtrl.translations['antibody.pdp.commerceCard.promotion.promocode']}}: {{promo.promoCode}} {{promo.promoTitle}} {{promo.promoDescription}}. {{$productOrderCtrl.translations['antibody.pdp.commerceCard.promotion.learnmore']}}
图: 1 / 6
AKT Pan Antibody (MA5-14999) in ICC/IF

Please note: We are reviewing Western blot images included in the antibody testing data in our catalog, including those provided by third parties. Unless expressly labeled or annotated as “raw-unedited”, Western blot images included in the antibody testing data in our catalog may have been edited, optimized or otherwise adjusted for presentation.
产品信息
MA5-14999
种属反应
已发表种属
宿主/亚型
分类
类型
克隆号
抗原
偶联物
形式
浓度
规格
纯化类型
保存液
内含物
保存条件
运输条件
RRID
产品详细信息
It is not recommended to aliquot this antibody.
This antibody is not cross-reactive with other related proteins.
靶标信息
AKT also known as protein kinase B (PKB) or RAS-alpha, is an ubiquitous serine/threonine kinase that plays an important role in diverse biological responses such as regulation of metabolism, cell survival and growth by phosphorylating multiple proteins. This protein kinase is activated by insulin, PI3K, IGF1 and various other growth and survival factors. Akt promotes cell survival by inhibiting apoptosis through phosphorylation and inactivation of several targets, including forkhead transcription factors, and caspase-9. The AKT pathway is a major target for cancer drug discovery.
仅用于科研。不用于诊断过程。未经明确授权不得转售。
生物信息学
蛋白别名: AKT1 kinase; Akt1m protein; AKT2 kinase; AKT3 kinase; DKFZp434N0250; kinase Akt1; MGC99656; murine thymoma viral (v-akt) oncogene homolog 1; murine thymoma viral (v-akt) oncogene homolog 2; pan akt; PKB; PKB alpha; PKB beta; PKB gamma; Protein kinase Akt-2; Protein kinase Akt-3; Protein kinase B; Protein kinase B alpha; Protein kinase B beta; Protein kinase B gamma; protein kinase B, beta; protein kinase B, gamma; protein kinase B-alpha; Proto-oncogene c-Akt; RAC protein kinase alpha RAC-PK alpha; RAC protein kinase beta; RAC protein kinase beta RAC-PK beta; RAC-alpha serine/threonine-protein kinase; RAC-beta serine/threonine protein kinase; RAC-beta serine/threonine-protein kinase; RAC-gamma serine/threonine-protein kinase; RAC-PK-alpha; RAC-PK-beta; RAC-PK-gamma; related to A and C kinases; STK-2; Thymoma viral proto-oncogene; thymoma viral proto-oncogene 1; thymoma viral proto-oncogene 2; thymoma viral proto-oncogene 3; v-akt murine thymoma viral oncogene 3; v-akt murine thymoma viral oncogene homolog 3 (protein kinase B, gamma)
基因别名: 2410016A19Rik; AI851531; Akt; AKT1; AKT2; AKT3; AW554154; D930002M15Rik; Nmf350; PKB; PKB/Akt; PKBalpha; PKBbeta; PKBG; RAC
UniProt ID: (Mouse) P31750, (Rat) P47196, (Rat) P47197, (Mouse) Q60823, (Rat) Q63484, (Mouse) Q9WUA6
Entrez Gene ID: (Mouse) 11651, (Rat) 24185, (Rat) 25233, (Mouse) 11652, (Rat) 29414, (Mouse) 23797




